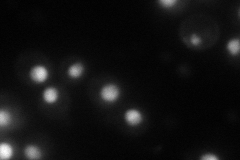
YDL106C
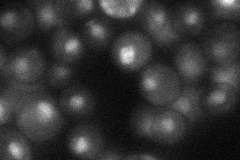
YDL106C
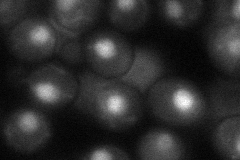
YDL106C
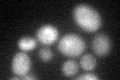
YDL106C

View description
Homeobox transcription factor; regulatory targets include genes involved in phosphate metabolism; binds cooperatively with Pho4p to the PHO5 promoter; phosphorylation of Pho2p facilitates interaction with Pho4p
Localization:
Intensity:
Fold change:
Significance:
-
C’ GFP library in SD

below threshold12.95 -
N' NOP1pr-GFP in SD
nucleus0 -
N' TEF2pr-mCherry in SD

nucleus85.2317 -
N' NATIVEpr-GFP in SD
nucleus29.416 -
N' TEF2pr-VC and Cyto-VN in SD
nucleus48.1698 -
C’ GFP library in SD+DTT
cytosol16.471.27No -
C’ GFP library in SD+H2O2

cytosol12.330.95No -
C’ GFP library in Starvation Media

cytosol18.881.45No -
C’ GFP library on the background of Pup2-DaMP

N/A -
C’ GFP library on the background of CCT mutant

N/A0N/AYes
